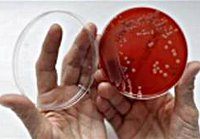

Другие названия и синонимы
Treatment of gardnerellosis.
Описание
Лечение Гарднерелла (бактериальный вагиноз) заключается в восстановлении вагинального микроканноза, который нарушается в результате увеличения условно-патогенных микроорганизмов (главным образом, Гарднерелла) во влагалищной среде и уменьшения или отсутствия лактобацилл. Гарднерелла, которая в небольших количествах присутствует во влагалище здоровых женщин, может доминировать на фоне снижения местного или общего иммунитета и негативно влиять на нормальную микрофлору влагалища. Длительный нелеченный Gardnerellosis может повредить внутренние половые органы.
|
|
Дополнительные факты
Показаниями к лечению Гарднерелла являются обнаружение Гарднереллы и наличие симптомов заболевания (зуд, секреция с «рыбным запахом»). Постоянные попытки устранить Гарднереллу антибиотиками хорошего здоровья могут привести к еще большему дисбалансу микрофлоры влагалища. При лечении Гарднерелла применяют общую и местную терапию.
Перед лечением Гарднереллы необходимо сдать мазок на степень чистоты и провести ПЦР-анализ на наличие скрытых инфекций, поскольку заболевание может развиваться на фоне уже существующих заболеваний, передающихся половым путем (включая венерические заболевания). У пациентов с хламидиозом и уреасплазмозом лечение сопутствующего гарднереллеза проводится после лечения основной инфекцией антибиотиками. Пациентам с сифилисом назначают антисифилитическую терапию с последующим лечением гарднереллой.
Перед лечением Гарднереллы необходимо сдать мазок на степень чистоты и провести ПЦР-анализ на наличие скрытых инфекций, поскольку заболевание может развиваться на фоне уже существующих заболеваний, передающихся половым путем (включая венерические заболевания). У пациентов с хламидиозом и уреасплазмозом лечение сопутствующего гарднереллеза проводится после лечения основной инфекцией антибиотиками. Пациентам с сифилисом назначают антисифилитическую терапию с последующим лечением гарднереллой.
|